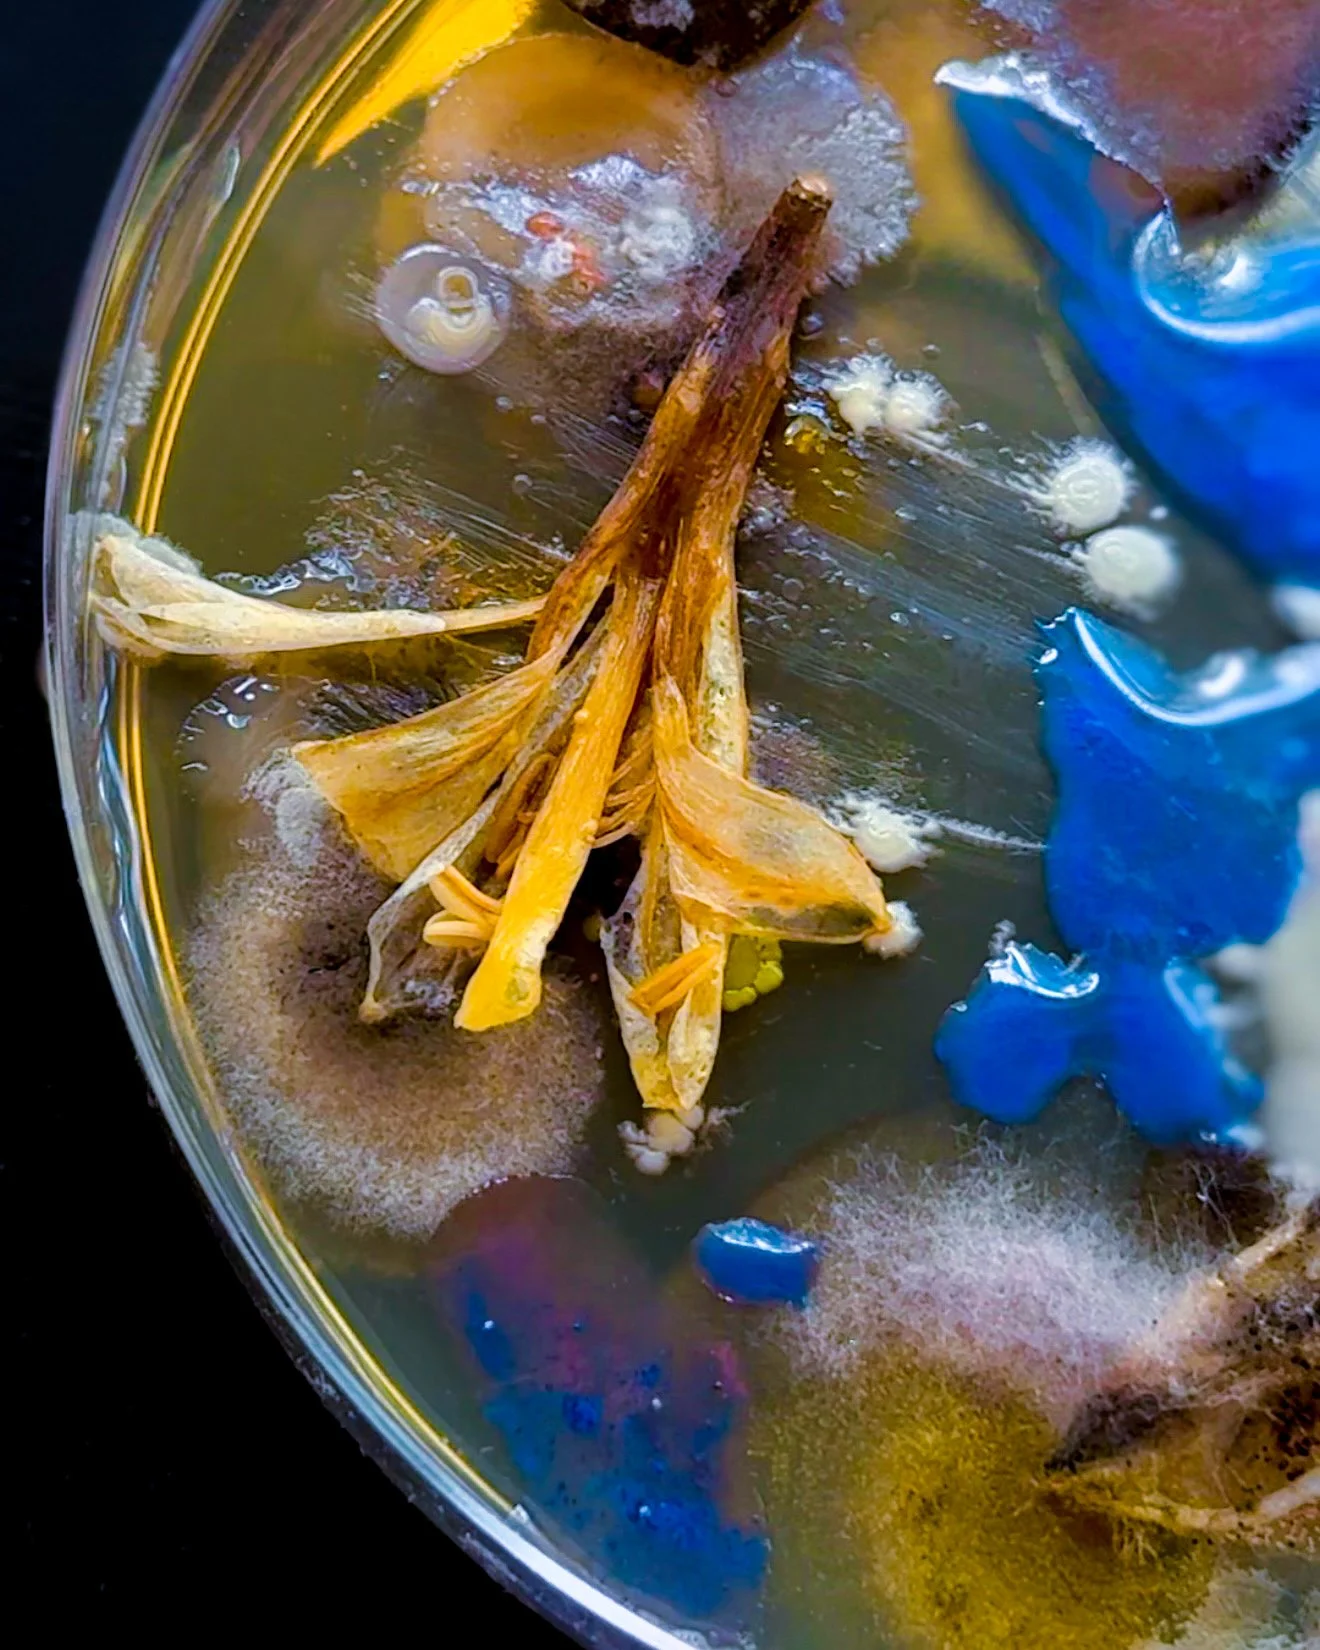

September 29, 2025
This week has been a strange balance between making and mending. On one side, I’ve poured myself into my creative work..sketching new concepts, pulling colors that feel alive, experimenting with textures that remind me of growth and resilience. There’s always something healing about turning an idea into form, about seeing my hands translate feeling into paint, pixels, or shape. Creativity feels like a lifeline, a reminder that beauty can rise even in heavy seasons.
But alongside that flow has been a very human ache. I’ve felt the sharp sting of sadness, the kind that sneaks up after moments of sweetness. The heart is complicated, it can hold both connection and hurt at the same time, and that paradox has been sitting with me all week. Sometimes, it’s hard not to ask how could both exist together? The answer doesn’t always come, but the question itself has shaped my art.
When I’m working with color, I’ve noticed I reach for contrasts: light laid against dark, warm tones brushed beside cooler shadows. Maybe I’m trying to paint what I can’t quite put into word that beauty and pain often live side by side, and the tension between them is what makes things feel real.
So this week, I’ve been creating not as an escape, but as a mirror. Each brushstroke and design choice is a way of saying: I’m still here, still feeling, still growing. The sadness doesn’t cancel out the joy of making, and the joy doesn’t erase the ache..they coexist, and maybe that’s the point.


September 10, 2025
Today I found myself staring at tiny worlds I didn’t expect to create. Circles of green, black, and pale fuzz…alive in ways both unsettling and mesmerizing.
There’s something humbling about mold. It grows quietly in the dark, unnoticed until it takes shape, a reminder that life persists in the smallest, strangest corners. It made me think about the parts of myself I’ve hidden away…the shadows I ignore, the feelings I try to contain. Like mold, they surface anyway, asking to be seen.
Maybe growth isn’t always pretty. Maybe it’s messy, uncomfortable, and even a little bit dangerous. But still…it’s proof of transformation, proof that something is happening beneath the surface.
I also went and picked up 3 commissions from the studio to matte and send off.

August 29, 2025
Today I checked in on the mold experiment I started three days ago, and it’s already taking on a life of its own. A few spores have begun sprouting, and there are clumps of soft white, round spots alongside fuzzier, web-like patches that almost look like cotton. The moth and flowers I placed inside are beginning to dry out, shifting the piece into this unexpected transformation. As I watched it change, an idea struck me: what if I encased the entire thing in resin and then painted over it? That intersection of decay, preservation, and layering feels like a direction worth exploring, so I’ll keep checking in as the process evolves.
In a different rhythm, I pulled out an old painting I didn’t feel connected to and gave it a second life with a fresh coat of deep violet-maroon. There’s something freeing about painting over what no longer serves me, letting it transform into something new. I’ll be working into its surface over the next few weeks and letting the color set the tone for what’s to come.
I also wrapped up my commission today: a triptych made from lumen prints and mushroom spore prints that I scanned and manipulated digitally, then painted over with oil flowers. That piece will be shipping out soon, and it feels good to send a part of my experimentation out into the world.
What I noticed most today was how much I enjoyed balancing multiple projects at once. Usually, I pressure myself to hyper-focus on a single canvas or idea, which often feeds my anxiety. But moving between mold, repainting, and finishing the commission gave me space to breathe. It reminded me that my creative process doesn’t have to be linear—it can be layered, flexible, and alive, just like the materials I work with.
